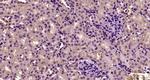
Desmoglein 2 Antibody in Immunohistochemistry (Paraffin) (IHC (P))

Search
Bioss
Desmoglein 2 Polyclonal Antibody
{{$productOrderCtrl.translations['antibody.pdp.commerceCard.promotion.promotions']}}
{{$productOrderCtrl.translations['antibody.pdp.commerceCard.promotion.viewpromo']}}
{{$productOrderCtrl.translations['antibody.pdp.commerceCard.promotion.promocode']}}: {{promo.promoCode}} {{promo.promoTitle}} {{promo.promoDescription}}. {{$productOrderCtrl.translations['antibody.pdp.commerceCard.promotion.learnmore']}}
图: 1 / 2
Desmoglein 2 Antibody (BS-10152R) in IHC (P)

产品信息
BS-10152R
种属反应
宿主/亚型
分类
类型
抗原
偶联物
形式
浓度
规格
纯化类型
保存液
内含物
保存条件
运输条件
靶标信息
Desmosomes are cell-cell junctions between epithelial, myocardial, and certain other cell types. Currently, three desmoglein subfamily members have been identified and all are members of the cadherin cell adhesion molecule superfamily. These desmoglein gene family members are located in a cluster on chromosome 18. This protein has been identified as the autoantigen of the autoimmune skin blistering disease pemphigus vulgaris.
仅用于科研。不用于诊断过程。未经明确授权不得转售。
篇参考文献 (0)
生物信息学
蛋白别名: ARVC10; ARVD10; Cadherin family member 5; CMD1BB; desmoglein 2; Desmoglein-2; DSG-2; HDGC; MGC117034; MGC117036; MGC117037
基因别名: AA408168; CDHF5; D18Ertd293e; DSG2; HDGC
UniProt ID: (Human) Q14126, (Mouse) O55111
Entrez Gene ID: (Human) 1829, (Mouse) 13511, (Rat) 307562




